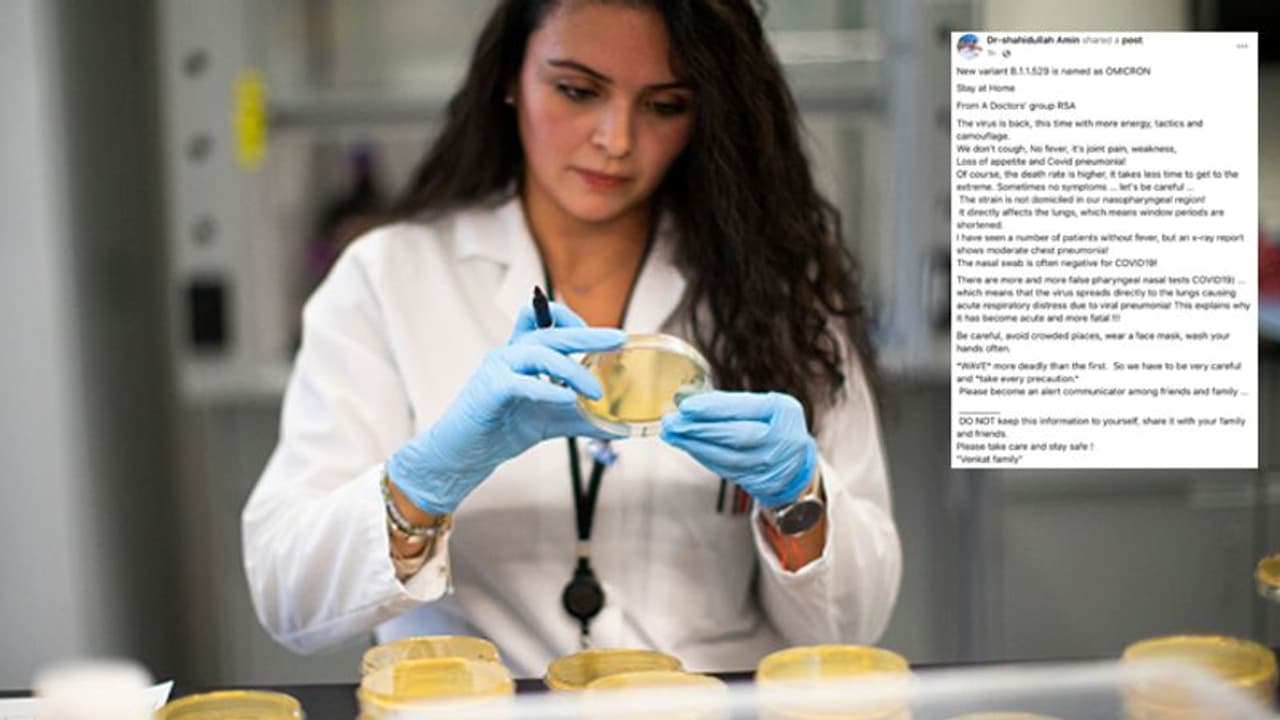
क्या RT PCR टेस्ट से भी Omicron का पता नहीं लग रहा? कोविड के नए Variant पर 5 बड़े झूठ वायरल क्या RT PCR टेस्ट से भी Omicron का पता नहीं लग रहा? कोविड के नए Variant पर 5 बड़े झूठ वायरल

Omicron Variant को लेकर पहला झूठ ये है कि इससे मौत का आंकड़ा बहुत तेजी से बढ़ा है, दूसरा आरटीपीसीआर टेस्ट से इसका पता नहीं लग रहा, तीसरा, इसका लक्षण पता नहीं चल रहा, चौथा कि ओमीक्रोन को लेकर कई रिसर्च सामने आ गई है और पांचवां कि ये दुनिया का सबसे खतरनाक वेरिएंट है।
क्या वायरल हो रहा है: इन दिनों सोशल मीडिया (Social Media) पर ओमीक्रोन (Omicron) को लेकर कई वीडियो और मैसेज वायरल हो रहे हैं। उनमें कुछ सच हैं तो कुछ फेक। ओमीक्रोन को लेकर एक न्यूज वायरल हो रही है कि ओमीक्रोन का आरटी पीसीआर (RT PCR) टेस्ट से भी पता नहीं लगाया जा सकता है। बता दें कि डब्ल्यूएचओ (WHO) ने कोरोना वायरस (Corona Virus) के नए स्ट्रेन ओमीक्रोन को एक वेरिएंट ऑफ कंन्सर्न करार दिया है। 24 नवंबर को साउथ अफ्रीका से ओमीक्रोन का पहला मामला सामने आया था। डब्ल्यूएचओ और दुनिया भर के वैज्ञानिक अभी इस नए स्ट्रेन (New Strain) को लेकर रिसर्च कर रहे हैं।
क्या है वायरल पोस्ट का सच:
- कई फेसबुक यूजर्स ने लिखा, "नए वेरिएंट बी.1.1.529 को ओमीक्रोन नाम दिया गया है। वायरस वापस आ गया है। इस बार ये और ज्यादा खतरनाक होकर वापस आया है। खांसी, बुखार, जोड़ों का दर्द नहीं होने पर भी इसके वायरल शरीर में मौजूद रह सकते हैं। इससे मृत्यु दर भी अधिक है। ये वायरल सीधे फेफड़ों को प्रभावित करता है। कई बार तो मरीज को बुखार भी नहीं आता। लेकिन वह ओमीक्रोन से संक्रमित पाया गया। एक्स-रे रिपोर्ट में देखने पर पता चला कि उसके लंग में संक्रमण था।"
- वायरल पोस्ट की पड़ताल करने से पहले बता दें कि ओमीक्रोन को लेकर WHO ये जरूर कहा है कि ये इससे रिस्क लेवल बहुत हाई है। ये भी सच है कि अभी तक ओमीक्रोन की वजह से किसी की मौत नहीं हुई है। इसके अलावा आरटीपीसीआर टेस्ट के जरिए ही संक्रमण का पता लगाया जा रहा है।
- वायरल पोस्ट में कहा गया है कि ओमीक्रोन से होने वाली मौत का आंकड़ा बहुत ज्यादा है। जबकि तमाम मीडिया रिपोर्ट्स से पता चलता है कि इससे अभी तक किसी भी मरीज की मौत नहीं हुई है। यहां तक कि साउथ अफ्रीका में भी इससे किसी की मौत नहीं हुई। साउथ अफ्रीका में ही ओमीक्रोन का पहला केस मिला था।
- दक्षिण अफ्रीका के डॉक्टर एंजेलिक कोएत्जी ने सबसे पहले अधिकारियों को ओमीक्रोन के बारे में बताया था। उन्होंने द टेलीग्राफ को बताया था कि नया वेरिएंट असामान्य लेकिन हल्का है। इसके अलावा ओमीक्रोन के मरीजों का स्वाद और गंध भी बनी रहती है। डब्ल्यूएचओ ने कहा है कि मौजूदा पीसीआर टेस्ट से ओमीक्रोन का पता लगाया जा सकता है। साउथ अफ्रीका और अन्य देशों में ओमीक्रोन का पता केवल आरटीपीसीआर टेस्ट के जरिए ही की गई है।
निष्कर्ष: ओमीक्रोन को लेकर सोशल मीडिया पर वायरल पोस्ट फेक है। पोस्ट में अनाम डॉक्टर्स के हवाले से फेक न्यूज फैलाई जा रही है। जबकि WHO ने पहले ही साफ कर दिया है कि ओमीक्रोन से बचने के लिए कोरोना की वैक्सीन बहुत जरूरी है। दुनिया में अभी कहीं पर भी ओमीक्रोन की वजह से किसी मरीज की मौत नहीं हुई है।
ये भी पढ़ें...
पति ने क्यों कहा, डिलीवरी के वक्त लेबर रूम में तुम्हारा देवर भी रहेगा, ये सुनकर भड़क गई पत्नी
मेरा चेहरा-होंठ सबकुछ कॉपी कर लिया, एडल्ट डॉल के लिए खुद के चेहरे के इस्तेमाल पर भड़की मॉडल
गजब का ऑफर: रोबोट में लगाने के लिए चेहरे की जरूर, छोटी सी शर्त पूरी करने पर मिलेंगे 1.5 करोड़ रुपए
Shocking: बेघर लड़की ठंड से बचने के लिए अपना जिस्म बेचती है, रात बीत जाए इसलिए पुरुषों के साथ सोती ह